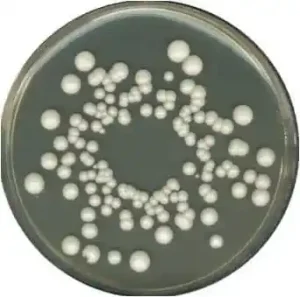

محیط کشت YGC Agar
محیط کشت YGC Agar کد 116000 یک محیط کشت مخصوص است که به عنوان یک محیط انتخابی برای جداسازی و شناسایی باکتریهای گرممثبت استفاده میشود. این محیط کشت اغلب برای جداسازی و شناسایی باکتریهای گوناگونی مانند Staphylococcus aureus، Bacillus subtilis و Bacillus cereus استفاده میشود.
YGC Agar شامل موادی مانند یونهای گلوکوز، یستات و کلرید آنیونیک میشود که به باکتریها به عنوان منبع انرژی و کربن مورد نیاز آنها ارائه میدهد. همچنین، حضور کلرید سدیم در این محیط میتواند اثری ضدمیکروبی داشته باشد.
شرکت دانش پژوهان شیمی وارد کننده اصلی مواد شیمیایی آزمایشگاهی بخصوص برند مرک آلمان و سیگماآلدریچ در ایران می باشد. جهت خرید محیط کشت می توانید با همکاران این مجموعه تماس حاصل نمائید.
محیط کشت YGC Agar
محیط کشت YGC آگار: راهنمای جامع برای میکروبیولوژیستها
ترکیب خاص این محیط کشت باعث میشود که باکتریهای گرممثبت با رنگ زرد که توسط فنوتیاز یا توسیلآز تولید میشوند، به راحتی قابل تشخیص و تمایز باشند. بنابراین، همچنین از این محیط برای آزمایش نمونههای که احتمال حضور باکتریهای گرممثبت را دارند، استفاده میشود.
در کل، محیط کشت YGC Agar یک ابزار مهم در آزمایشگاههای میکروبیولوژی است که امکان جداسازی و تشخیص باکتریهای گرممثبت را فراهم میکند.
محیط کشت YGC آگار (Yeast Glucose Chloramphenicol Agar) که به اختصار YGC agar نیز نامیده میشود، یک محیط کشت انتخابی و افتراقی است که برای جداسازی و تمایز مخمرها و کپکها، به خصوص از شیر و محصولات لبنی، استفاده میشود.
ترکیبات محیط کشت YGC Agar:
- عصاره مخمر: منبع نیتروژن، کربن، ویتامینها و مواد معدنی ضروری برای رشد مخمرها و کپکها.
- دکستروز: منبع کربوهیدرات و انرژی برای مخمرها و کپکها.
- آگار: عامل ژل کننده که به محیط کشت قوام جامد میدهد.
- کلرامفنیکل: آنتیبیوتیکی که رشد باکتریها را مهار میکند و محیط کشت را به صورت انتخابی در میآورد.
عملکرد محیط کشت YGC Agar:
- انتخابی: کلرامفنیکل در YGC آگار، رشد باکتریها را مهار میکند و به جداسازی مخمرها و کپکها از نمونههای آلوده به باکتری کمک میکند.
- افتراقی: YGC آگار فاقد عوامل افتراقی اختصاصی است، بنابراین تمایز بین مخمرها و کپکها بر اساس مورفولوژی کلنی و سایر تستهای بیوشیمیایی انجام میشود.

خرید محیط کشت YGC Agar
شرکت دانش پژوهان شیمی که نمایندگی مرک آلمان و نمایندگی سیگماآلدریچ در ایران، با همکاری کارشناسان مجرب خود در بخش فنی و فروش، جهت تامین مواد اولیه پژوهش های تحقیقاتی ماده های با کیفیت بالا و قیمت مناسب را فراهم نموده است. شما می توانید جهت خرید محیط کشت YGC Agar با بخش فروش شرکت دانش پژوهان شیمی تماس حاصل بفرمایید و پس از دریافت پیش فاکتور و اطمینان حاصل نمودن از صحت نام محصول، کد، شماره CAS نامبر مواد شیمیایی درخواستی اقدام به ثبت سفارش نمایید تحویل کالاهای خریداری شده و زمان تحویل آنها به صورت زیر می باشد.
زمان ارسال سفارشات از انبار: ۲۴ تا ۴۸ ساعت کاری می باشد
نحوه ارسال کالای مشتریان: تهران توسط پیک
ظاهر کلنی ها:
- مخمرها: کلنیهای گرد، صاف، براق و به رنگ کرم یا سفید
- کپکها: کلنیهای پرزدار، خشن و به رنگهای مختلف مانند سفید، سیاه، سبز و قهوهای
کاربردهای محیط کشت YGC Agar:
- جداسازی و تمایز مخمرها و کپکها از شیر و محصولات لبنی
- بررسی کیفیت میکروبیولوژیکی شیر و محصولات لبنی
- شمارش مخمرها و کپکها در مواد غذایی
- تحقیقات میکروبیولوژی مربوط به مخمرها و کپکها
مزایای محیط کشت YGC Agar:
- حساسیت بالا برای مخمرها و کپکها
- سهولت استفاده
- مقرون به صرفه
معایب محیط کشت YGC Agar:
- ممکن است برخی از سویههای مخمر و کپک را مهار کند
- تمایز بین مخمرها و کپکها فقط بر اساس مورفولوژی کلنی و سایر تستهای بیوشیمیایی امکانپذیر است
محدودیت ها:
- YGC آگار فقط برای جداسازی و تمایز اولیه مخمرها و کپکها استفاده میشود. برای تأیید هویت نهایی، باید از آزمایشهای بیوشیمیایی و مولکولی استفاده شود.
- YGC آگار برای تشخیص عفونتهای قارچی در انسان یا حیوان توصیه نمیشود.
نتیجه گیری:
YGC آگار یک ابزار ارزشمند برای جداسازی و تمایز مخمرها و کپکها از نمونههای مختلف، به خصوص شیر و محصولات لبنی، است. این محیط کشت به دلیل حساسیت بالا، سهولت استفاده و مقرون به صرفه بودن، به طور گسترده در آزمایشگاههای میکروبیولوژی مواد غذایی و محیطی مورد استفاده قرار میگیرد.
فروش محیط کشت YGC Agar
شرکت دانش پژوهان شیمیی یکی از بزرگترین وارد کنندگان و فروشندگان مواد شیمیایی و آزمایشگاهی بخصوص فروش محیط کشت YGC Agar می باشد. این شرکت در زمینه واردات این محصولات از تجربه بسیار بالایی برخوردار است. شما می توانید جهت تهیه این محصولات (اصلی) با بخش فروش شرکت تماس گرفته و با کارشناسان این شرکت در ارتباط باشید و یا از طریق کانال واتساپ شرکت نام محصول به همراه میزان نیاز خود را ارسال تا در کمترین زمان پاسخ استعلام خود را دریافت نمائید.امیدواریم بتوانیم با ارائه محصولات اصلی و با بهترین کیفیت شما را برای رسیدن به اهدافتان یاری نمائیم.
جهت محصولات بیشتر واستعلام سریع قیمت محیط کشت YGC Agar میتوانید از طریق کانال واتساپ شرکت با ارسال نام ماده و مقدار نیاز در کمترین زمان پاسخ استعلام خود را دریافت نمائید.
راههای ارتباطی
شماره های تماس:
021-66859216
021-66859220 (ساعات تماس:8.30 الی 19)
واتساپ:09129618292 (24ساعت)
Last Updated on 08/01/2024 by adminm


